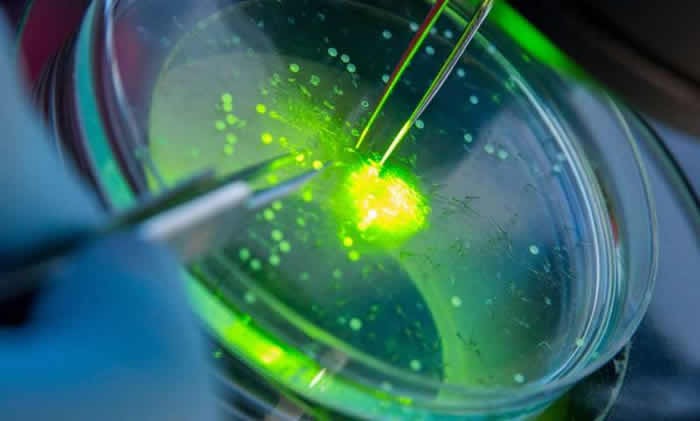

It has recently been shown that molybdenum disulfide (MoS2), may have a two-dimensional (2D) form that is similar to graphene, even though it is ubiquitously used as a solid lubricant. However, when it is thinned down to less than a nanometer thick, MoS2 demonstrates properties with great promise as a functional material for electronic devices and surface coatings.
The University of Illinois at Urbana-Champaign researchers have developed a new approach to dynamically tune the micro- and nano-scale roughness of atomically thin MoS2, and consequently the appropriate degree of hydrophobicity for various potential MoS2-based applications.
“The knowledge of how new materials interact with water is a fundamental,” explained SungWoo Nam, an assistant professor of mechanical science and engineering at Illinois. “Whereas the wettability of its more famous cousin, graphene, has been substantially investigated, that of atomically thin MoS2 – in particular atomically thin MoS2 with micro- and nano-scale roughness – has remained relatively unexplored despite its strong potential for fundamental research and device applications. Notably, systematic study of how hierarchical microscale and nanoscale roughness of MoS2 influence its wettability has been lacking in the scientific community.”
Jonghyun Choi, a mechanical engineering graduate student and first author of the article, ‘Hierarchical, Dual-Scale Structures of Atomically Thin MoS2 for Tunable Wetting,’ appearing in the journal, Nano Letters said: “This work will provide a new approach to dynamically tune the micro- and nano-scale roughness of atomically thin MoS2 and consequently the appropriate degree of hydrophobicity for various potential MoS2-based applications.”
Choi continued: “These include waterproof electronic devices with superhydrophobicity with water contact angle greater than 150°. It may also be useful for medical applications with reduced hydrophobicity (WCA less than 100°) for effective contact with biological substances. ”
According to the authors, this study, expands the toolkit to allow tunable wettability of 2D materials, many of which are just beginning to be discovered.
“When deformed and patterned to produce micro- and nano-scale structures, MoS2 shows promise as a functional material for hydrogen evolution catalysis systems, electrodes for alkali metal-ion batteries, and field-emission arrays,” Nam added. “The results should also contribute to future MoS2-based applications, such as tunable wettability coatings for desalination and hydrogen evolution.”
More information: EurekAlert!